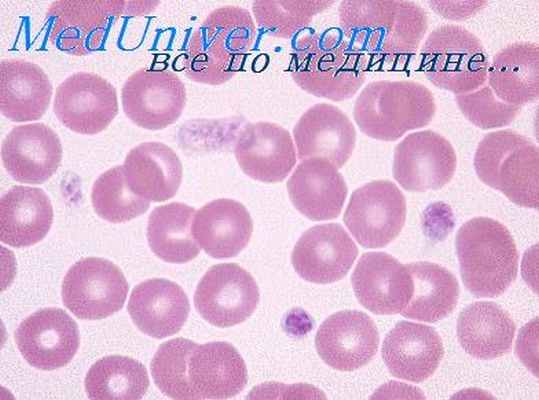
тромбоцитопатии новорожденных

Тромбоцитопатии новорожденных. Ангиопатии новорожденных и плода
Добавил пользователь Владимир З. Обновлено: 13.12.2025
Некротическая флегмона новорожденных. Морфология флегмоны новорожденных
Некротическая флегмона (флегмона новорожденных) — тяжелое заболевание детей периода новорожденности, выражающееся в быстро прогрессирующем распространенном некрозе и воспалении подкожной клетчатки различных областей тела. Заболевание впервые описали А. С. Васильев (1937) и О. С. Бокастова (1939). Возбудители — разнообразные кокки и палочки, особенно золотистый и белый стафилококк, а также поливалентная флора.
Патогенез заболевания неясен. Молниеносное распространение и развитие заболевания у доношенных, полновесных детей, наличие предшествующих воспалительных процессов говорят о иммунопатологических реакциях. Быстрая некротизация тканей связана с распространенным тромбозом сосудов. Способствует распространению поражения обильная сеть лимфатических сосудов в подкожной клетчатке новорожденного.
Заболевание начинается с ухудшения состояния и подъема температуры до 39—40 °С. На коже спины, груди, живота, пояснично-крестцовой области или ягодиц, реже в других областях появляется красноватое пятно, которое быстро, за несколько часов, распространяется на значительные участки (до 1/4 поверхности тела).

Через 1—3 сут определяется уплотнение кожи и подкожной клетчатки, которое в отличие от рожистого воспаления западает по сравнению с нормальной кожей. Образуются свищевые ходы. Отторжение некротизированных тканей происходит в конце 1-й или начале 2-й недели болезни. Выражена интоксикация. Летальность, составлявшая ранее до 70% [Бокастова О. С, 1939], снизилась до 14% и даже 6% [Каипов Ф. И., Остромоухова Г. А., 1971; Баиров Г. А., 1973].
На ранних этапах заболевания отмечаются небольшой отек дермы, лимфогистиоцитарная инфильтрация вокруг мелких сосудов и придатков кожи, фибриноидный некроз мелких сосудов, кровоизлияния. Подкожная клетчатка при развитии некроза становится тусклосерой или желтоватой, не кровоточит. Кожа вначале отслаивается, но не некротизируется.
Микроскопически на границе некротической зоны имеется скудная лейкоцитарная инфильтрация, главным образом вокруг протоков, волосяных фолликулов и сосудов. Затем присоединяется некроз кожи, и она отторгается. Образуются крупные дефекты с подрытыми, неровными краями. Дно покрыто некротизированной жировой клетчаткой, видны мышцы, а местами — кости, которые также могут быть вовлечены в воспалительно-некротический процесс (деструктивный остеомиелит и миозит).
В окружающих тканях распространенная лейкоцитарная инфильтрация, тромбоваскулит, а позже — гранулематозная реакция с макрофагами и гигантскими клетками инородных тел, фагоцитирующими продукты распада жира — жировые капли и кристаллы. Возможно распространение некроза на брюшную или плевральные полости, перикард, развитие сепсиса, раневого истощения, образование метастатических очагов в других органах (абсцедируюшая пневмония, гнойный менингит, нефрит). Заживление обширных дефетков тканей происходит медленно, с развитием грубых, иногда деформирующих рубцов.
- Читать далее "Некротический энтероколит новорожденных. Мекониевый перитонит плода"
Тромбоцитопатии новорожденных. Ангиопатии новорожденных и плода
Тромбоцитопатии новорожденных. Ангиопатии новорожденных и плода
Амегакариоцитарная тромбоцитопения, сочетающаяся с пороками органов, характеризуется резкой тромбоцитопенией из-за снижения количества или отсутствия мегакариоцитов в костном мозге. Кроме этого, обычно имеется тот или иной порок развития, в том числе костные аномалии, чаще — отсутствие лучевой кости, что обусловливает косорукость. Возможны пороки сердца и других органов. Геморрагические явления появляются в первые 24 ч жизни или позже. Прогноз неблагоприятен, больные умирают в первые недели или месяцы жизни.
Макроцитарная тромбоцитопатия с тромбоцитопенией (синдром Бсрнара-Сульс)—заболевание с аутосомно-рецес-сивиым наследованием, сопровождающееся геморрагическим диатезом. Количество тромбоцитов нормальное или снижено, они увеличены в размерах (гигантские), до 8,1 мкм в диаметре. Уплотненный большой хромо-мер, напоминающий ядро, делает их похожими на лимфоциты. Гипертрофированная и расширенная цитоплазматическая сеть создает в световом микроскопе картину вакуолизации.
Макроцитарная тромбоцитопения с нефритом и глухотой наследуется аутосомно-доминантно. Кровоточивость, тяжелый нефрит и глухота выявляются с 1-го месяца жизни. В последующем возможно спонтанное уменьшение геморрагических явлений.
Синдром серых пластинок — рецессивное, сцепленное с Х-хромосомой заболевание. В крови мальчиков с первых месяцев жизни выявляются гигантские серые (при гематологических окрасках) тромбоциты.
Тромбастения Гланцманна — аутомосно-рецессивное заболевание. Число тромбоцитов нормальное, но в связи ее снижением активности их ферментов изменено содержание АТФ. Это нарушает агрегацию пластинок и приводит к геморрагиям. Заболевание редко проявляется ,в периоде новорожденности.
Приобретенные тромбоцитопении. Тромбоцитопении потребления связаны с повышенной элиминацией тромбоцитов при синдроме диссеминированного внутрисосудистого свертывания или при синдроме Казабаха —Мерритта. Изоиммунные тромбоцитопении обусловлены действием материнских антител против тробоцитов плода. Тромбоцитопения матери при этом не обязательна. Течение обычно благоприятное. Токсические тромбоцитопении вызваны употреблением беременной или кормящей женщиной различных лекарственных веществ, угнетающих образование тромбоцитов (хинин, ПАСК и др.). Tромбоцитопения при врожденном лейкозе связана с вытеснением из костного мозга мегакариоцитов лейкозиыми инфильтратами [Kunzer W., 1966]. Тромбоцитопения при болезни Верльгофа имеется у 40% детей, родившихся от матерей, страдающих этим заболеванием [Мазурин А. В., 1974]. Кроме обычных признаков геморрагического диатеза, имеются тромбоцитопения, увеличение длительности кровотечения. Страдают как девочки, так и мальчики.
Ангиопатии — врожденные или приобретенные заболевавания, кровеноспых сосудов, которые могут сопровождаться геморрагическими явлениями. Причины заболеваний изучены недостаточно. Проявляются они главным образом в первые 3 сут жизни. Характерна множественность кровоизлияний. Патогенез повышенной кровоточивости при ангиопатиях сложен. Наряду с непосредственным повреждением сосудов (воспалительного или другого генеза) имеет значение диспротеинемия, тромбоцитопения, гиповитаминоз К, поражение печени, сопровождающееся снижением продукции фибриногена и других факторов. Участие этих компонентов в каждом отдельном случае различно.
Наследственные ангиопатии в период новорожденности проявляются очень редко. К ним относятся болезнь Рандю-Ослера — Вебсра и синдром Элерса—Данлоса.
Приобретенные ангиопатии встречаются часто, особенно при внутриутробных инфекционных заболеваниях — сепсисе, цитомегалии, сифилисе, токсоплазмозс, листериозе и других, а также при врож генном лейкозе.
Информация на сайте подлежит консультации лечащим врачом и не заменяет очной консультации с ним.
См. подробнее в пользовательском соглашении.
Геморрагические диатезы:
– это геморрагический диатез, в основе которого лежит нарушение сосудистых механизмов гемостаза.
По происхождению бывают:
Наследственные ангиопатии:
Телеангиэктазии – наследуется по доминантному признаку и представляет собой недостаточно прочную сосудистую стенку с образованием в ней выпячиваний и аневризмов, которые могут разрываться и служить причиной кровотечения.
Болезнь Виллебранда – наследуется по аутосомно-доминантному признаку и проявляется дефектом образования тромбадгезина.
Приобретенные ангиопатии:
– развиваются на основе аутоиммунного конфликта с развитием васкулитов.
Геморрагический капилляротоксикоз – болезнь Шенляйн-Геноха – происходит образование аутоантител к эндотелию сосудов→разрушение интимы→ее геалиновое перерождение→образование периваскулярных воспалительных инфильтратов вплоть до некрозов→кровотечение
абдоминальная, кожная, суставная, церебральная, молниеносная.
Повреждение сосудистой стенки комплексом АГ+АТ при иммунокомплексных аллергических реакциях (сывороточная болезнь).
Ангиопатии при гиповитаминозе вит.С, необходимого для синтеза гиалуроновой кислоты и глюкокортикоидов. Глюкокортикоиды – «цемент» базальной мембраны от состояния которой зависит проницаемость сосудистой стенки. ГК подавляют активность фермента гиалуронидазы, который вызывает деполимеризацию гиалуроновой кислоты, и тем самым стабилизируют сосудистую стенку и снижают ее проницаемость.
Токсические ангиопатии при эндогенных интоксикациях (уремия, желтуха).
Возрастное нарушение питания сосудистой стенки.
Ангиопатия при нарушении питания (недостаток белка в пище).
Тромбоцитопатии:
Собственно тромбоцитопатии– нарушение функции тромбоцитов.
Тромбоцитопении (мегакариоцитарная, амегакариоцитарная)
Амегакариоцитарная тромбоцитопенияразвивается при нарушении тромбоцитопоэза в костном мозге и сопровождается снижением количества мегакариоцитов.
Причины: действие на костный мозг радиации, лекарственных препаратов (цитостатики), интоксикация, вытеснение и отравление мегакариоцитарного ростка (при лейкозах, метастазах опухолей в костный мозг).
Мегакариоцитарная тромбоцитопатия– мегакариоцитарный росток в норме, но повышено разрушение тромбоцитов вне костного мозга.
Болезнь Верльгофа – чаще в 25-35 лет у девушек. Проявляется склонностью к кровотечениям из слизистых, петехиальной сыпи, ломкостью сосудов.
Вырабатываются аутоантитаела к собственным тромбоцитам → развивается их лизис, происходит нарушение отшнуровки тромбоцитов от мегакариоцитов → резковыраженная тромбоцитопения.
Лекарственная тромбоцитопения. Многие лекарственные в-ва являются гаптенами и, адсорбируясь на тромбоцитах, изменяют их антигенный состав → вырабатываются аутоантитела, которые разрушают тромбоциты. В отличие от б.Верльгофа – исчезает после прекращении принятия лек.препаратов.
Гиперспленическая тромбоцитопения развивается при увеличении размеров селезенки. Селезенка разрушает тромбоциты, происходит угнетение тромбоцитопоэза.
Неонатальная (у плода, у новорожденных) – временная, развивается по 2-м механизмам: а) в организме матери вырабатываются антитела к тромбоцитам ребенка, б) у матери тромбоцитопения в следствие образуются АТ, которые попадают к плоду. После рождения происходит восстановление.
Собственно тромбоцитопатиятрудно поддается диагностике, выделяют:
Тромбастения Гланцмана – отсутствие в оболочке тромбоцита комплекса гликопротеинов (IIв-IIIа-рецепторов), необходимых для взаимодействия со стимулятором агрегации тромбоцитов фибриногеном. Адгезия не нарушается, нарушается агрегация тромбоцитов.
Тромбоцитодистрофия – недостаточный синтез третьего фактора (тромбоцитарного фактора 3)- материала для реакций коагуляционного гемостаза, на нем происходит образование протромбиназы.
Геморрагические диатезы
Существует целый ряд синдромов, основным симптомом которых является повышенная кровоточивость ‒ то есть склонность к обширным кровоизлияниям после незначительных травм, а также спонтанным и повторным кровотечениям. Эта группа заболеваний называется геморрагическими диатезами. Коды по МКБ-10 ‒ от D69 до D69.9.

Патогенез
Причиной геморрагических диатезов является нарушение одного из этапов гемостаза ‒ физиологического процесса, обеспечивающего остановку кровопотери. В зависимости от того, какой именно этап оказался нарушен, ГД подразделяют на:
- Ангиопатии (вазопатии). Сюда относятся диатезы, вызванные дефектами сосудистых стенок. В норме при повреждении рядом с местом разрыва сосуд сокращается, затем меняются свойства его стенок, они становятся липкими. Это необходимо, чтобы к ним могли приклеиваться тромбоциты. Данный механизм нарушается при таких ГД, как геморрагический васкулит, болезнь Рандю-Ослера-Вебера, а также при нехватке в организме витамина С.
- Тромбоцитопатии, т.е. заболевания, связанные с дефектом тромбоцитарного звена системы свертывания. Тромбоциты могут вырабатываться в недостаточном количестве или, в результате изменения своих функциональных свойств, слишком быстро разрушаться. При обоих вариантах развития событий адгезия тромбоцитов к стенкам сосудов оказывается затруднена. Это характерно для тромбоцитопенической пурпуры, лейкоза, тромбоцитопении, геморрогической алейкии и т.д.
- Гемофилии (коагулопатии). В данной группе заболеваний речь идет о нарушении плазменного звена гемостаза. То есть того этапа, когда в крови запускается последовательный каскад реакций, вследствие которых белок фибриноген превращается в нерастворимый фибрин. Сюда относится гемофилия, парагемофилия, ДВС-синдром, врожденная афибриногенемическая пурпура и т.д.
Этиология перечисленных выше дефектов гемостаза может быть различной. Выделяют врожденные нарушения, связанные с наследственными патогенетическими факторами, и приобретенные.
Наследственные проявляются еще в детском возрасте. Обычно ребенка приводят в педиатрию с симптомами родители.
Приобретенные называют симптоматическими, потому что обычно они являются проявлением или осложнением какого-то другого заболевания: системной красной волчанки, цирроза печени и др. Их дебют может состояться лишь в пожилом возрасте.
Клиническая картина
Основное проявление геморрагического диатеза ‒ кровотечения. В зависимости от их характера предлагается следующая классификация:
Капиллярный (микроциркуляторный)
Характеризуются как безболезненные мелкие поверхностные кровоизлияния в кожу и слизистую. Проявляется это как синяки, петехии, носовые и маточные кровотечения, кровоточивость десен.
Гематомный
Речь идет об обширных кровоизлияниях в суставы, мышцы, мягкие ткани пациента. В результате возникают весьма болезненные гематомы, способные привести к расслоению тканей, деформирующим артрозам, переломам. Данный вид кровотечений весьма характерен для гемофилии.
Капиллярно-гематомный (смешанный)
Такой тип характерен для ДВС-синдрома, болезни Виллебранда, передозировки антикоагулянтами. Представляет собой сочетание мелких внешних кровоизлияний то типу микроциркуляторных и крупные подкожные гематомы.
Васкулитно-пурпурный
Выглядят как мелкая точечная сыпь руках, ногах, бедрах, туловище. Как правило, она оказывается распределена по телу симметрично. Сопровождаются слабо выраженным отеком. Остаточная пигментация после таких высыпаний остается долго. Этот симптом характерен для геморрагического васкулита.
Ангиоматозный
Сюда относятся устойчивые, рецидивирующие кровотечения одной-двух локализаций. Чаще всего носовые, но иногда желудочно-кишечные, легочные. Частным случаем ангиоматозных кровоизлияний также является гематурия ‒ кровь в моче.
Естественным следствием кровопотери часто становится анемия, которая сопровождается повышенной утомляемостью, головокружениями, бледной кожей, потерей массы тела, лихорадкой.
Возможные негативные последствия
Помимо анемии, следствием ГД может стать:
- Иммунные нарушения;
- Утрата подвижности одной части тела или нескольких;
- Потеря зрения вследствие кровоизлияний в сетчатку;
- Поражение внутренних органов, ведущее к ухудшению их работы;
- Анемическая кома.
Это серьезное заболевание. Важно при первых его признаках как можно скорее обратиться к врачу, пройти диагностику, аккуратно следовать рекомендациям. При необходимости, лечь в клинику, где вам обеспечат необходимый сестринский уход и своевременное лечение.
Диагностика
Геморрагические диатезы ‒ это множество заболеваний со сходной симптоматикой. Притом эти заболевания очень различны по этиологии, последствиям, возможным осложнениям, методу лечения. Поэтому очень важно верно поставить дифференциальный диагноз. Для этого специалисты прибегают к:
- Физиликальному осмотру. Это необходимо для определения типа кровоизлияний, их локализации. Зафиксировать наличие или отсутствие отека, болезненность суставов и т.п.
- Лабораторным тестам. Общий анализ крови позволяет выявить снижение числа эритроцитов, тромбоцитов, падение уровня гемоглобина. Анализ мочи и кала призван обнаружить скрытые кровоизлияния, если они присутствуют. Биохимическое исследование крови дает возможность комплексно оценить параметры ее свертываемости.
- Инструментальной диагностике. Например, к трепанобиопсии, стернальной пункции. Это процедуры, позволяющие получить образец костного мозга для анализа его кроветворной функции.
Исходя из особенностей течения болезни, могут быть назначены и другие диагностические процедуры: тест Кумбса, функциональные пробы на ломкость капилляров, УЗИ почек, УЗИ печени и т.д.
Для постановки корректного диф диагноза желательно участие в процессе специалистов разных профилей: иммунолога, ревматолога, гематолога, гинеколога.
Лечение
Терапия варьируется для разных диагнозов. Можно условно объединить медицинские меры, к которым прибегают в данном случае, в следующие большие разделы:
Остановка кровотечения
Прежде, чем приниматься за лечение, необходимо разобраться с основным симптомом ‒ с кровотечением. Для этого используют жгуты, давящие повязки, гемостатические губки, прикладывание холода.
Гемокомпонентная терапия
Т.е. переливание плазмы, тромбоцитарной или эритроцитарной массы. К таким мерам прибегают лишь при острой необходимости, когда жизненно необходимо восполнить дефицит факторов свертывания. Может иметь негативные последствия для иммунитета.
Прием препаратов
Это могут быть глюкокортикоиды при тромбоцитопатиях, витамины при проблемах с сосудистыми стенками, медикаментозные средства, обеспечивающие нормальную свертываемость крови. Также используется широкий спектр препаратов для борьбы с побочными эффектами основного лечения.
Хирургическое вмешательство
Обращение к подобным мерам может быть обусловлено:
- Повторяющимися массивными кровопотерями;
- Повреждениями сосудов из-за постоянных кровотечений;
- Повреждением суставов.
Диетотерапия
Пациентам с ГД необходимо полноценное, высококалорийное питание, богатое витаминами С, PP, кальцием и железом. Это в первую очередь яйца, молочные продукты, рыба, овощи. Врач, исходя из конкретной ситуации, подробнее расскажет, какой диеты надлежит придерживаться пациенту, напишет памятку.
На этапе восстановления к перечисленным медицинским мерам присоединяется лечебная физкультура.
Теоретические и клинические аспекты тромбоцитопении новорожденных
Рассмотрены причины и механизмы развития тромбоцитопений у новорожденных, описан алгоритм диагностического поиска в случае выявления тромбоцитопении, приведен пример клинического наблюдения новорожденного с диагнозом «изоиммунная тромбоцитопеническая пурп
Causes and mechanims of newborns' thrombocytopenia development have been analysed, algprithm of diagnostic process in case of thrombocytopenia revealing has been described, case of clinical observation of newborn with diagnosis thrombocytopenic isoimmune purpura has been reviewed.
К тромбоцитопениям относят состояния, при котором количество тромбоцитов периферической крови составляет менее 150 × 10 9 /л. Это довольно частый гематологический синдром в неонатальном периоде. У 1–5% детей тромбоцитопения регистрируется при рождении, но только у 0,1–0,5% новорожденных она является тяжелой (количество тромбоцитов менее 50,0 × 10 9 /л) [1, 2]. Примерно в половине случаев тромбоцитопения проявляется геморрагическим синдромом.
Причины тромбоцитопений у новорожденных весьма вариабельны [3]. Это могут быть первичные тромбоцитопении, в основе которых, как правило, лежат иммунопатологические процессы. Вторичные (симптоматические) тромбоцитопении возникают на фоне различных состояний, среди которых чаще вирусные или бактериальные инфекции, тяжелые гипоксические проявления, иммунодефицитные состояния, синдром внутрисосудистого свертывания крови и др. Все формы тромбоцитопенической пурпуры по механизму возникновения являются приобретенными, даже в случаях рождения ребенка с клинической картиной тромбоцитопенической пурпуры.
Механизмы развития тромбоцитопений в неонатальном периоде различны. Среди них выделяют:
1. Повышенное разрушение тромбоцитов — в результате иммунных процессов:
а) изоиммунная (аллоиммунная) тромбоцитопеническая пурпура. Развитие данного заболевания схоже с гемолитической болезнью, однако иммунологический конфликт обусловлен несовместимостью плода и матери по тромбоцитарным антигенам (чаще всего по PLA1-антигену, который отсутствует у матери). В сенсибилизированном материнском организме появляются антитромбоцитарные антитела, которые, проникая через плаценту, вызывают разрушение тромбоцитов у плода. Изосенсибилизация может быть как при повторной, так и при первой беременности. Встречается с частотой 1 случай на 1000 новорожденных [4];
б) трансиммунная тромбоцитопеническая пурпура развивается у детей, родившихся от матерей, страдающих аутоиммунной тромбоцитопенией. Это бывает при идиопатической тромбоцитопенической пурпуре, системной красной волчанке, аутоиммунном тиреоидите, синдроме Эванса и др. Аутоантитела матери проникают через плаценту и вызывают разрушение тромбоцитов у плода. Поскольку после рождения ребенка проникновение антител от матери к ребенку прекращается, то данная форма заболевания имеет благоприятный прогноз.
Механическое разрушение тромбоцитов в результате повышенного их потребления в кавернозных сосудистых образованиях встречается при синдроме Казабаха–Мерритта.
2. Повышенное потребление тромбоцитов при синдроме внутрисосудистого свертывания крови, искусственной вентиляции легких, гемолитико-уремическом синдроме.
3. Недостаточная продукция тромбоцитов — а-, гипомегакариоцитозы. Выделяют исключительно амегакариоцитарные тромбоцитопении, которые не сочетаются с какими-либо другими видами патологии. Гипомегакариоцитозы — сочетаются или с синдромом отсутствия лучевой кости (ТАР-синдром), или с другими костными и органными дефектами и дисплазиями. Панцитопении — когда а-, гипомегакариоцитоз сочетается с аплазией других ростков кроветворения, с различными нарушениями пигментации, врожденными аномалиями скелета, глаз, ушей, сердца.
Помимо вышеперечисленных механизмов и форм заболевания выделяют гетероиммунные тромбоцитопении, при которых антитела вырабатываются против чужого антигена, расположенного на поверхности тромбоцитов. Примером чужеродного антигена являются лекарства, вирусы. Также возможно развитие тромбоцитопении в результате изменения антигенной структуры тромбоцитов, под влиянием вирусного воздействия. После выведения лекарства из организма или выздоровления от вирусной инфекции признаки болезни исчезают и больной выздоравливает.
Развитию тромбоцитопении новорожденных способствует и ряд токсических и лекарственных форм, употребляемых беременными женщинами. В их числе — алкоголь, тиазидные препараты, гидралазин, сульфаниламиды, фуразолидон, фенилбутазон, эстрогены, гепаринотерапия и др.
Механизм развития тромбоцитопений при внутриутробных инфекциях довольно сложен и связан с недостаточной продукцией тромбоцитов костным мозгом, угнетением мегакариоцитарного ростка токсинами возбудителя, гиперспленизмом, ДВС-синдромом.
Алгоритм диагностического поиска в случае выявления тромбоцитопении у новорожденного предусматривает:
1) сбор анамнестических данных: у матери — наличие аутоиммунной тромбоцитопении (идиопатическая тромбоцитопеническая пурпура, системная красная волчанка, аутоиммунный тиреоидит, синдром Эванса и др.); аномалий плаценты (хориоангиоматоз, отслойка, тромбоз), применения лекарственных препаратов. У новорожденного — преморбидный фон (гипоксические состояния, недоношенность, задержка внутриутробного развития (ЗВУР), переношенность и т. д.); наличие основного заболевания (внутриутробная инфекция, иммунодефицитные состояния, гигантская гемангиома и т. д.);
2) определение характера тромбоцитопении — первичности или вторичности;
3) изучение клинических данных: геморрагический синдром в первые дни жизни ребенка в виде кожных проявлений (петехии, экхимозы), кровотечений из микроциркуляторного русла (носовые, десневые и пр.), кровотечения из пуповинного остатка, мелена. Для геморрагического синдрома при тромбоцитопениях характерны спонтанность, несимметричность, полиморфность и полихромность. Локализацию кровоизлияний в склерах и конъюнктиве следует расценивать как прогностически неблагоприятный признак в плане возникновения кровоизлияний в головной мозг. При трансиммунной форме геморрагический синдром постепенно идет на спад, поскольку поступление антитромбоцитарных антител к ребенку от матери прекращается и разрушения тромбоцитов не происходит [5]. В случае вторичных тромбоцитопений геморрагии развиваются на фоне основного заболевания, характерным симптомом является гепатосленомегалия. Выраженность геморрагического синдрома у новорожденных при ТОRCH-инфекциях зависит не только от возбудителя, но и от гестационного возраста, в котором плод подвергся действию инфекционного агента. Для синдрома Казабаха–Меррита характерно развитие мелены новорожденных;
4) оценку лабораторных показателей. О наличии тромбоцитопении свидетельствует:
- число тромбоцитов в периферической крови менее 150 × 10 9 /л на фоне нормальных других ее показателей;
- увеличение продолжительности кровотечения по Дуке более 4 мин;
- снижение ретракции кровяного сгустка менее 60%;
- гиперплазия мегакриоцитарного ростка (более 54–114 в 1 мкл) в миелограмме;
- отсутствие отклонений в лабораторных тестах, характеризующих коагуляционное звено гемостаза.
Обнаружение антитромбоцитарных антител подтверждает иммунный характер заболевания. Выявление диагностически значимого повышения титра антител к какому-либо возбудителю (цитомегаловирусу (ЦМВ), вирусу Эпштейна–Барр, вирусу краснухи, простого герпеса и др.) подтверждает вторичность тромбоцитопении (гетероиммунные формы заболевания).
Только последовательное и тщательное проведение всех этапов диагностического поиска позволяет врачу получить четкое представление о происходящих в организме ребенка процессах и выработать правильную тактику лечения.
Наличие геморрагического синдрома независимо от характера тромбоцитопений (первичный или вторичный) ставит в основу лечебных мероприятий купирование геморрагических проявлений.
При иммунных тромбоцитопениях в случае легкого течения заболевания, сопровождающегося только кожным синдромом. В качестве препаратов выбора служат ангиопротекторы — этамзилат 12,5% раствор по 0,1 мл/кг в/в или в/м 2–4 раза в сутки или по 500 мг 4–6 раз в сутки внутрь. Фармакологическое действие препарата связано с повышением устойчивости капилляров, уменьшением их проницаемости, улучшением микроциркуляции, а также стимуляцией образования фактора свертывания крови III, нормализации адгезии тромбоцитов [6]. Ингибиторы фибринолиза — эпсилон-аминокапроновая кислота в дозе 50 мг/кг в/в капельно один раз в сутки. Ее действие базируется на торможении активирующего влияния стрептокиназы, урокиназы и тканевых киназ на фибринолиз, нейтрализации эффектов калликреина, трипсина и гиалуронидазы, уменьшении проницаемости капилляров [6]. Подавление иммунопатологического процесса достигается путем применения глюкокортикоидов — преднизолон в дозе не менее 2 мг/кг в сутки в два приема. Возможно проведение альтернативной терапии — иммуноглобулины человека нормальные (Иммуновенин, Пентаглобин, Октагам) в дозе 0,4 г/кг в сутки в/в в течение 5 дней. Положительный эффект иммуноглобулинов обусловлен блокадой Fc-рецепторов макрофагов, что уменьшает опсонизацию тромбоцитов и предотвращает их разрушение в кровеносном русле. Применение иммуноглобулинов позволяет получить более быстрый (через 24–48 часов), но менее стойкий эффект, чем при применении глюкокортикоидов. Поэтому довольно часто прибегают к комбинированному использованию этих препаратов. Однако по данным зарубежных авторов использование преднизолона и иммуноглобулинов при аллоиммунной форме заболевания остается дискутабельным [7, 8].
В случае развития жизнеугрожающих кровотечений показано применение тромбоцитарного концентрата. К его применению необходим тщательный и взвешенный подход, поскольку при иммунных формах переливание тромбоконцентрата противопоказано, т. к. его использование может еще больше усугубить процесс в связи с избыточным образованием антител. Показанием к трансфузии тромбоцитов является число тромбоцитов менее 20/нл без признаков кровотечения и менее 30/нл при признаках кровотечения [7]. Расчетной дозой для переливания тромбоконцентрата является 10 мл/кг, однако оптимальная доза может быть получена при проведении индивидуального математического расчета в пересчете на один из параметров (массу тела, объем циркулирующей крови, площадь тела). После трансфузии необходим контроль уровня тромбоцитов. Клиническим критерием эффективности трансфузий тромбоконцентрата служит купирование геморрагического синдрома, увеличение количества тромбоцитов у больного через 1 час после трансфузии не менее чем на 50–60 × 109/л и удержание результата через 24 часа.
При вторичных тромбоцитопениях необходимо проводить терапию основного заболевания, поскольку прогноз определяется именно его течением.
Таким образом, диагностика тромбоцитопений новорожденных является весьма сложным процессом, грамотное проведение которого во многом предопределяет успех терапевтических мероприятий, а следовательно — прогноз и качество жизни пациента.
Приводим собственное клиническое наблюдение новорожденного с диагнозом «изоиммунная тромбоцитопеническая пурпура», которая была диагностирована у ребенка с сопутствующим заболеванием — врожденным пороком сердца.
Анамнез жизни. От первой беременности, протекала на фоне кандидозного кольпита. Обследование на пренатальные инфекции, обнаруживались антитела класса IgG к вирусу простого герпеса 1-го типа. Роды в срок, масса при рождении 3060 г, длина 53 см. К груди приложен сразу, сосал активно. При рождении на коже отмечались множественные элементы от петехий до экхимозов, местами сливные. В раннем неонатальном периоде желтуха физиологическая появилась на третьи сутки жизни, уровень общего билирубина 170 мкмоль/л, глюкоза — 4,3 ммоль/л, C-реактивный белок (СРБ) менее 5 нг/мл. Максимальная убыль первоначальной массы тела составила 8,5%, пупочный остаток отпал на четвертые сутки жизни. Отмечалась легкая неврологическая симптоматика в виде снижения рефлекторной активности, мышечной гипотонии. Гемограмма в первые сутки жизни: гемоглобин 150 г/л, эритроциты — 4,6 × 10 12 /л, цветовой показатель — 0,9, лейкоциты — 9,4 × 10 9 /л, палочкоядерные нейтрофилы — 3%, сегментоядерные — 65%, лимфоциты — 27%, моноциты — 4%, эозинофилы — 1%. СОЭ 3 мм/час. В течение раннего неонатального периода кожно-геморрагический синдром сохранялся и имел тенденцию к усилению в виде появления новых элементов. Проведено лечение: этамзилат, менадиона натрия бисульфит (Викасол), фототерапия. В связи с отсутствием положительной динамики ребенок переведен на второй этап лечения.
При поступлении. Состояние тяжелое. Кожа бледно-розовая, акроцианоз, периорбитальный цианоз в покое, геморрагии по всему туловищу от мелкоточечных до экхимозов 3–4 см в диаметре, полихромные. Слизистые оболочки неба, глотки, конъюнктивы, склеры чистые. Со стороны внутренних органов: дыхание через нос свободное, при аускультации над всей поверхностью легких проводится пуэрильное дыхание, хрипов нет, перкуторно — коробочный оттенок перкуторного звука, частота дыхания 45 в минуту. Область сердца визуально не изменена, при аускультации сердечные тоны приглушены, ритм сохранен, частота сердечных сокращений 123 в минуту. Живот при пальпации мягкий, печень у края реберной дуги, селезенка не пальпируется. Пупочная область без особенностей. Стул, диурез не нарушены. В течение последующих трех дней сохранялось прежнее состояние, на туловище множественные геморрагии, в т. ч. и «свежие», аппетит снижен. Со стороны сердца при аускультации во втором межреберье слева грудины выслушивался систолический шум средней интенсивности. Печень +3,5 см из-под края реберной дуги, селезенка +1,0 см. Масса тела 2850 г.
Обследование. Динамика результатов гемограммы представлена в таблице.
СОЭ на протяжении всей госпитализации не превышала 6 мм/час. Анализ мочи без отклонений от нормы (пятикратно). В биохимическом анализе крови уровень СРБ менее 10 нг/мл, печеночные пробы в норме, умеренная гипопротеинемия. Иммуноферментный анализ (ИФА) на специфические антитела к антигенам ЦМВ — отрицательные, ИФА на специфические антитела к антигенам вируса Эбштейна–Барр — отрицательные, ИФА с герпесвирусами 1-го, 2-го типа — IgМ — отрицательные, IgG — положительный, индекс авидности 72%. ИФА на специфические антитела к хламидийному антигену — отрицательные, ИФА с микоплазменным антигеном — отрицательные, ИФА к токсоплазменному антигену — отрицательные. В коагулограмме: протромбиновый тест — международное нормализованное отношение (МНО) — 1,0, протромбиновый индекс (ПТИ) — 100%, протромбиновое время — 15,3 сек; фибриноген — 1,62 г/л, тромбиновое время — 16 сек. Миелограмма на 14-е сутки жизни (5-й день госпитализации): бластные клетки 0,5%, индекс созревания нейтрофилов — 1,0, индекс созревания эритрокариоцитов — 0,8, лейкоэритробластические соотношения — 1,3:1,0 (норма 2,1:4,5). Заключение: тип кроветворения нормобластический. Отшнуровка тромбоцитов слабо выражена, имеется много мегакариоцитов разной степени зрелости.
Исследование крови у матери отклонений в гемограмме не выявило.
На электрокардиограмме признаки гипертрофии правого желудочка и межжелудочковой перегородки. ЭХО-КГ-исследование: выявлены дополнительная трабекула левого желудочка, дефект межпредсердной перегородки 6 мм, сброс крови слева направо. Сократительная способность миокарда желудочков удовлетворительная, фракция выброса 68%. УЗИ органов брюшной полости: печень 53 мм, структура однородная. Селезенка размер 44 × 26 мм, структура однородная. Почки: слева — лоханка 7 мм, размер 46 × 21 мм, справа — размер 45 × 22 мм. Нейросонография: гипоксические изменения и признаки незрелости структур головного мозга.
Таким образом, данный клинический пример демонстрирует сложность интерпретации клинико-лабораторных показателей у детей периода новорожденности. Лабораторная диагностика иммунных тромбоцитопений во многих лечебных учреждениях нашей страны еще недостаточно развита. Только четкий алгоритм диагностического поиска позволит врачу достаточно быстро и четко оценить все многообразие причин, приводящих к развитию тромбоцитопений новорожденных и оперативно и правильно назначить адекватную терапию. Поэтому распространение информации о патогенезе и существующих методах исследования различных форм иммунных тромбоцитопений и внедрение этих методов в клиническую практику является необходимым условием улучшения диагностики и повышения эффективности лечения этих заболеваний.
Литература
- Масчан А. А., Румянцев А. Г. Иммунно-опосредованные тромбоцитопении новорожденных: дифференциальный диагноз и принципы терапии // Вопросы гематологии/онкологии и иммунопатологии в педиатрии. 2010, т. 9, № 3, с. 13–18.
- Пшеничная К. И. Врожденные тромбоцитопатии у детей: особенности диагностики, симптоматики и лечения: Автореф. дисс. д-ра мед. наук. СПб, 2002. 28 с.
- Шабалов Н. П. Неонатология: Учебн. пособие. Т. 2. М.: МЕДпресс-информ. 2004. 640 с.
- Durand-Zaleski I., Schlegel N., Blum-Boisgard C. et al. Screening primiparous women and newborns for fetal/neonatal alloimmune thrombocytopenia: a prospective comparison of effectiveness and costs. Immune Thrombocytopenia Working Group // Am J Рerinatol. 1996; 13 (7): 423–431.
- Головко О. К., Линчевский Г. Л., Воробьева О. В. Клинические аспекты иммунных тромбоцитопений в неонатологии // Здоровье ребенка. 2006. № 2. С. 115–122.
- Регистр лекарственных средств. М.: РЛС-2005. 1440 с.
- Рооз Р. Неонатология. Практические рекомендации: пер. с нем. М.: Мед. лит. 2011. 592 с.
- Berkowitz R. L., Kolb E. A., McFarland J. G. et al. Parralel randomized trials of risk-based therapy for fetal alloimmune thrombocytopenia // Am. J. Obstet Gynecol. 2006; 107 (1): 91–96.
Н. М. Судакова*, доктор медицинских наук, профессор
Н. И. Гревцева**
О. М. Зубов**
О. В. Лазарева**
* Белгородский государственный университет, **МУЗ «Городская детская больница», Белгород
Читайте также:
